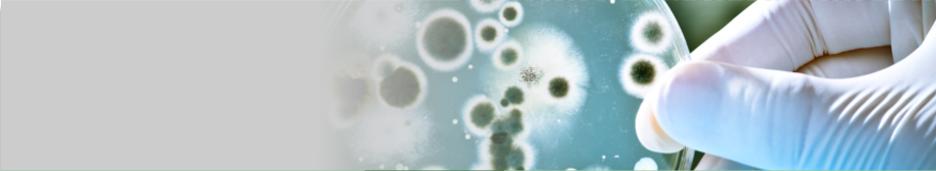

Erstellung von Infrarotbildern zur Feststellung von:
Wärmebrücken an Gebäuden
fehlerhaften Solarmodulen
fehlerhaften elektrischen Bauteilen
Luftdichtigkeit von Gebäuden
Schäden an Gebäuden:
Wasserschaden, Leitungsbruch...
Erstellung von Infrarotbildern zur Feststellung von:
Wärmebrücken an Gebäuden
fehlerhaften Solarmodulen
fehlerhaften elektrischen Bauteilen
Luftdichtigkeit von Gebäuden
Schäden an Gebäuden:
Wasserschaden, Leitungsbruch...


 Die Wärmebildkamera macht Wärmebrücken am Gebäude sichtbar.
Schlecht isolierte Bauteile oder mangelhaft ausgeführte Arbeiten
können als Wärmebrücken zu hohem Wärmeverlust, oder auch zur
Kondensationsbildung im Gebäude führen.
Durch die erhöhte Feuchtigkeit entsteht schnell Schimmelpilzbildung.
Die Wärmebildkamera macht Wärmebrücken am Gebäude sichtbar.
Schlecht isolierte Bauteile oder mangelhaft ausgeführte Arbeiten
können als Wärmebrücken zu hohem Wärmeverlust, oder auch zur
Kondensationsbildung im Gebäude führen.
Durch die erhöhte Feuchtigkeit entsteht schnell Schimmelpilzbildung.




 Mit der Wärmebildkamera können an Photovoltaikmodulen fehlerhafte
Sektoren sichtbar gemacht werden. Eine jährliche Überprüfung mittels
einer Wärmebildkamera und einer elektrischen Messung sichert dem
Betreiber der Anlage eine vollständige Funktion und die maximale
Leistung der PV-Anlage zu. Eine erweiterte Anlagensicherheit bietet
die Installation eines SolarLog, der im Störungsfall sofort eine Meldung
per SMS und/oder e-mail versendet. Alle Daten werden aufgezeichnet
und können in einer Statistik abgelesen werden.
Fehlerhafte elektrische Bauteile können mit der Wärmebildtechnik
frühzeitig erkannt werden.
Durch eine abnormale Erwärmung wird schon vor einem Ausfall des Bauteils
ein bevorstehender Schaden erkannt. Neben einer bestehenden Brandgefahr,
kann auch frühzeitig der Ausfall von Maschinen und Geräten erkannt und
verhindert werden.
Mit einem BlowerDoor-Test wird die Luftdichtigkeit von Gebäuden gemessen.
Aufgrund einströmender Kaltluft kann die Wärmebildkamera die undichten
Stellen am Gebäude sichtbar machen und somit direkt die Ursache der
Undichtigkeit feststellen.
Feuchtigkeitsschäden und Leitungsbrüche können ohne Beschädigung der
Bausubstanz lokalisiert werden.
Schäden an Fußbodenheizungsrohren oder Fernwärmenetzen lassen sich
mit einer Wärmebildkamera einfach identifizieren.
Wärmebrücken an Gebäuden
Fehlerhafte Solarmodule
Fehlerhafte elektrische Bauteile
Luftdichtigkeit von Gebäuden
Schäden an Gebäuden:
Wasserschaden, Leitungsbruch...
Mit der Wärmebildkamera können an Photovoltaikmodulen fehlerhafte
Sektoren sichtbar gemacht werden. Eine jährliche Überprüfung mittels
einer Wärmebildkamera und einer elektrischen Messung sichert dem
Betreiber der Anlage eine vollständige Funktion und die maximale
Leistung der PV-Anlage zu. Eine erweiterte Anlagensicherheit bietet
die Installation eines SolarLog, der im Störungsfall sofort eine Meldung
per SMS und/oder e-mail versendet. Alle Daten werden aufgezeichnet
und können in einer Statistik abgelesen werden.
Fehlerhafte elektrische Bauteile können mit der Wärmebildtechnik
frühzeitig erkannt werden.
Durch eine abnormale Erwärmung wird schon vor einem Ausfall des Bauteils
ein bevorstehender Schaden erkannt. Neben einer bestehenden Brandgefahr,
kann auch frühzeitig der Ausfall von Maschinen und Geräten erkannt und
verhindert werden.
Mit einem BlowerDoor-Test wird die Luftdichtigkeit von Gebäuden gemessen.
Aufgrund einströmender Kaltluft kann die Wärmebildkamera die undichten
Stellen am Gebäude sichtbar machen und somit direkt die Ursache der
Undichtigkeit feststellen.
Feuchtigkeitsschäden und Leitungsbrüche können ohne Beschädigung der
Bausubstanz lokalisiert werden.
Schäden an Fußbodenheizungsrohren oder Fernwärmenetzen lassen sich
mit einer Wärmebildkamera einfach identifizieren.
Wärmebrücken an Gebäuden
Fehlerhafte Solarmodule
Fehlerhafte elektrische Bauteile
Luftdichtigkeit von Gebäuden
Schäden an Gebäuden:
Wasserschaden, Leitungsbruch...

Wärmebildtechnik
Wärmebildtechnik
